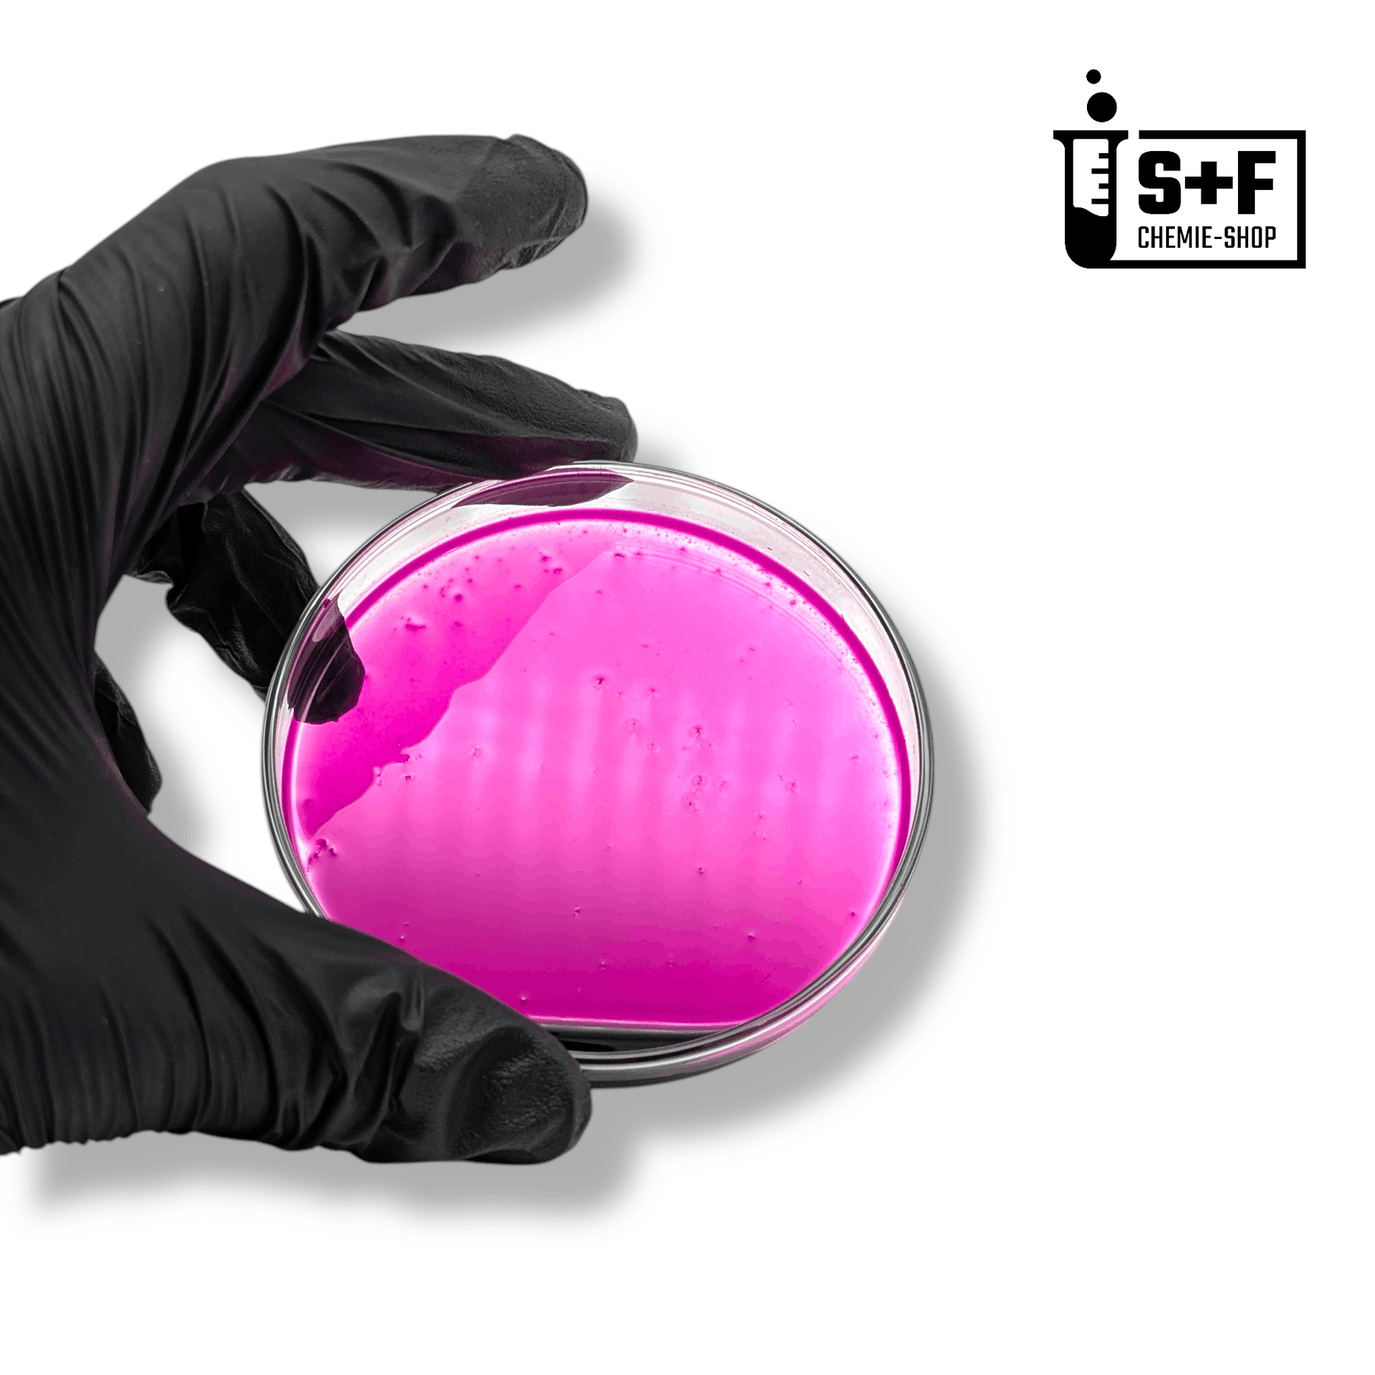
Herstellung einer Kaliumpermanganat-Lösung - S+F Chemie-Shop

S+F Chemie-Shop
Herzlich Willkommen im S+F Chemie-Shop!
Hier finden Sie unterschiedlichste Chemikalien mit diversen Anwendungsmöglichkeiten für Privatpersonen und Endverbraucher. Wir legen höchsten Wert auf die Qualität unserer Produkte & die Zufriedenheit unserer Kunden! Alle unsere Produkte werden in Deutschland abgefüllt und aus Deutschland innerhalb kürzester Zeit zu Ihnen nach Hause geliefert. Viel Freude beim Shoppen wünscht,
Das Team von S+F Chemie-Shop
Entdecken Sie unsere Chemikalien:







Kupfersulfat-Pentahydrat (CuSO₄·5H₂O)
1–3 Tage Lieferung 📦
Exzellenter Kundenservice ⭐️
- 99,9% | Schwefel Pulver -
Unser bester Schwefel
1,5 kg - Schwefel (S) | Schwefelpulver | anorganisch
5 kg - Schwefel (S) | Schwefelpulver | anorganisch
3,5 kg - Schwefel (S) | Schwefelpulver | anorganisch
Unsere Bestseller
2 kg - Kupfersulfat Pentahydrat (CuSO₄·5H₂O)
1 kg - Kupfersulfat Pentahydrat (CuSO₄·5H₂O)
5 kg - Kupfersulfat Pentahydrat (CuSO₄·5H₂O)
3,5 kg - Kupfersulfat Pentahydrat (CuSO₄·5H₂O)














Unsere neusten Blogartikel
Erfahren Sie mehr über unsere Chemikalien, deren Anwendungen und viele interessante Informationen
Fragen oder Produktanfragen? - Schreiben Sie uns! 📩
S+F Chemie-Shop in Zahlen:
Verkaufte Produkte 📦
🏆 Zufriedene Kunden
FAQ:
📦 Wie lange dauert die Lieferung meiner Bestellung?
"Die Lieferzeiten können je nach Ihrem Standort und der Art der bestellten Chemikalien variieren. In der Regel beträgt die Lieferzeit 1-3 Werktage. ⏱️ Sobald Ihre Bestellung versandt wurde, erhalten Sie eine Versandbestätigung mit einer Sendungsverfolgungsnummer per E-Mail. Weitere Informationen zu unseren Versandbedingungen finden Sie hier. 🚚"
📍Woher kommen die Produkte und wo werden Sie abgefüllt?
"Unsere Chemikalien beziehen wir ausschließlich von zertifizierten Partnern aus der EU.🇪🇺 Abgepackt und versendet werden die Chemikalien mit viel ❤️ in Deutschland.🇩🇪"
↩️ Kann ich einen gekauften Artikel zurückgeben und wenn ja, wie lange?
"Ja! Ungeöffnete Produkte können bei uns problemlos innerhalb von 30 Tagen nach Erhalt, ohne Angabe von Gründen zurückgegeben werden, sofern sie sich im Originalzustand befinden und die Verpackung unbeschädigt ist. Bitte kontaktieren Sie unseren Kundenservice 💬 um die Rücksendung zu arrangieren und eine Anleitung für die nötigen Schritte zu erhalten. Bitte beachten Sie, dass geöffnete Chemikalien aus Sicherheitsgründen und aufgrund gesetzlicher Bestimmungen nicht zurückgegeben werden können."
⭐️ Wie kann ich sicherstellen, dass die von mir gekauften Produkte von hoher Qualität sind?
"Wir beziehen unsere Chemikalien ausschließlich von zertifizierten und vertrauenswürdigen Herstellern aus der EU. 🇪🇺 Alle Produkte durchlaufen strenge Qualitätskontrollen, bevor sie in unser Lager aufgenommen werden. Zusätzlich bieten wir detaillierte Produktspezifikationen und zahlreiche Informationen für unsere Chemikalien an, um Ihnen maximale Transparenz und Sicherheit zu gewährleisten. ✅"
💳 Welche Zahlungsmethoden kann ich verwenden?
"Wir akzeptieren eine Vielzahl von Zahlungsmethoden, um Ihnen den Einkauf so bequem wie möglich zu machen. Dazu gehören Kreditkarten, PayPal, Banküberweisungen/ Kauf auf Rechnung (über Klarna), sowie Apple Pay, Google Pay und Shop Pay. Alle Transaktionen sind durch modernste Sicherheitsmaßnahmen geschützt, damit Ihre Daten jederzeit sicher sind. 🔒"
🔐 Sind meine Daten im S+F Chemie-Shop sicher?
"Ja, Ihre Sicherheit hat für uns oberste Priorität. Wir verwenden moderne Verschlüsselungstechnologien und halten uns an die höchsten Sicherheitsstandards, um Ihre persönlichen und Zahlungsinformationen zu schützen. Ihre Daten werden nur für den Zweck Ihrer Bestellung verwendet und nicht an Dritte weitergegeben. ✅"




![Kaliumnitrat (KNO₃) - [1 kg - 10 kg] - S+F Chemie - Shop - Chemikalie](http://sf-chemie-shop.de/cdn/shop/files/kaliumnitrat-kno3-1-kg-10-kg-sf-chemie-shop-chemikalie-9665268.jpg?v=1760009510&width=2048)